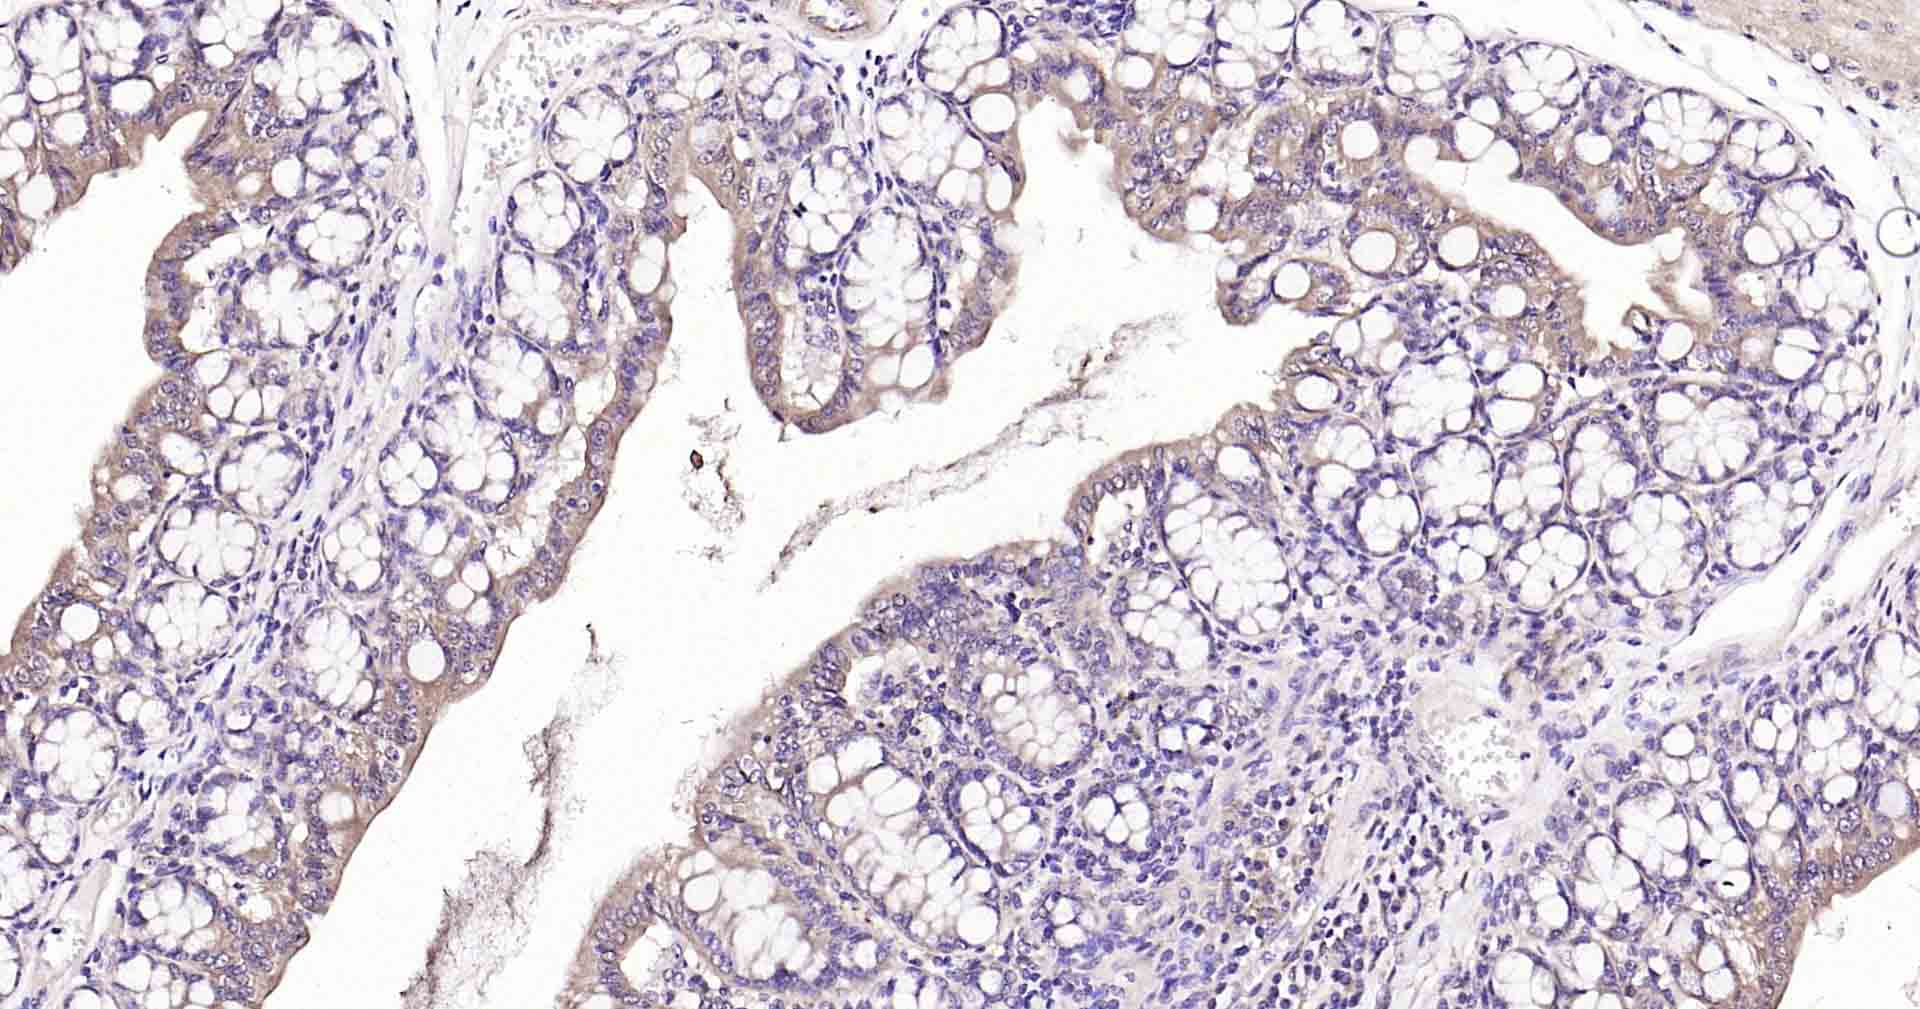
蛋白酪氨酸磷酸酶-1B重组兔单抗
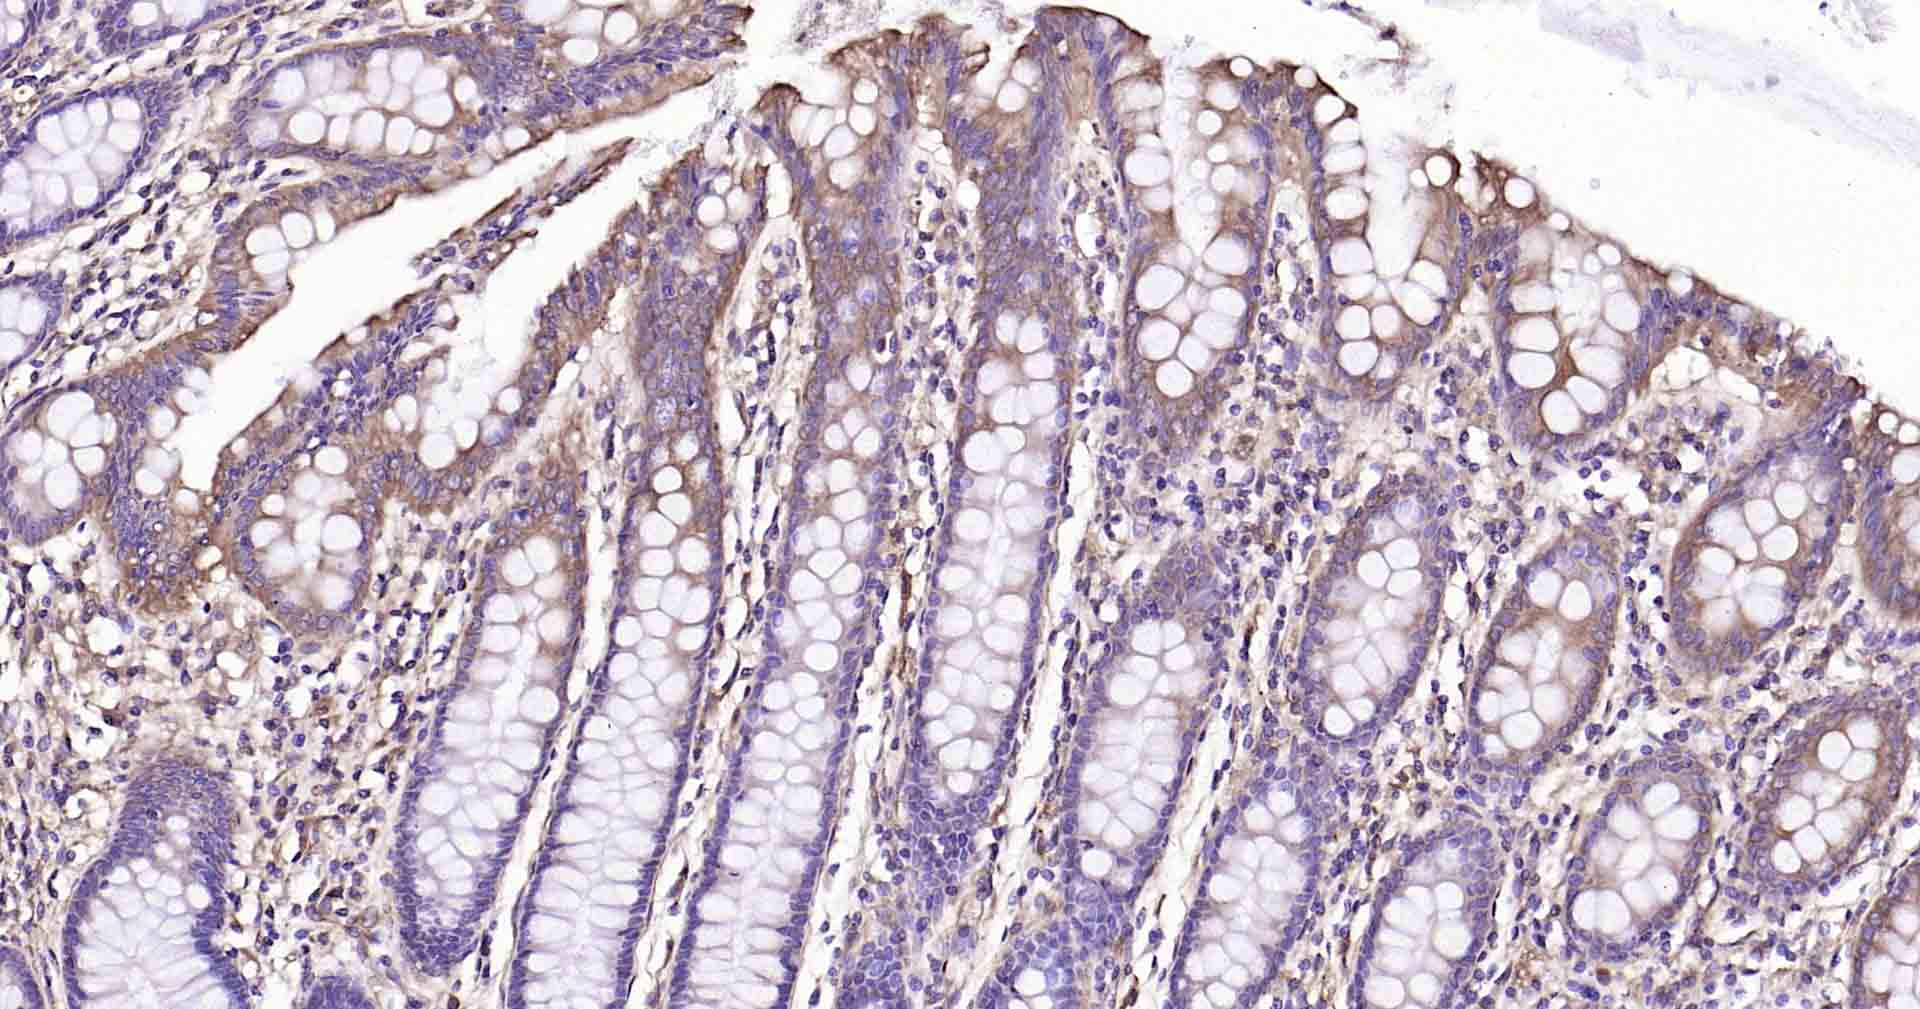
蛋白酪氨酸磷酸酶-1B重组兔单抗

蛋白酪氨酸磷酸酶-1B重组兔单抗
Rrmab?兔单抗

货号:bsm-60700R
产品详情
相关标记
相关产品
相关文献
常见问题
概述
产品编号
bsm-60700R
产品类型
重组兔单抗
英文名称
PTP1B Recombinant Rabbit mAb
中文名称
蛋白酪氨酸磷酸酶-1B重组兔单抗
英文别名
PTP1B; PTP-1B; PTP-HA2; Ptp; PTN1_HUMAN; PTPN1; Protein-tyrosine phosphatase 1B (PTP-1B); 3.1.3.48; PTN1_MOUSE; Protein-tyrosine phosphatase HA2 (PTP-HA2); PTN1_RAT;
抗体来源
Rabbit
免疫原
A synthesized peptide derived from human PTPN1: 350-400
亚型
IgG
性状
Liquid
纯化方法
affinity purified by Protein A
克隆类型
Recombinant
克隆号
R3F5
理论分子量
50 kDa
浓度
1mg/ml
储存液
0.01M TBS (pH7.4) with 1% BSA, 0.02% Proclin300 and 50% Glycerol.
研究领域
SWISS
Gene ID
保存条件
Shipped at 4℃. Store at -20℃ for one year. Avoid repeated freeze/thaw cycles.
注意事项
This product as supplied is intended for research use only, not for use in human, therapeutic or diagnostic applications.
数据库链接
产品介绍
蛋白酪氨酸磷酸酶1B(PTP1B)是一种胰岛素信号的负性调节因子,与肥胖症和2型糖尿病的发病及发展关系密切。对P-tyr基因敲除小鼠的研究表明,缺失PTP1B小鼠的胰岛素敏感性明显增加,并对肥胖有一定的抵抗作用,而另一些对动物和人体的研究结果却与此相反,发现PTP1B可通过引起胰岛素抵抗、瘦素抵抗及影响脂代谢等而导致肥胖症和2型糖尿病的发生。一些特异性的Ptyr小分子抑制剂已经开发并用于肥胖和糖尿病的治疗中。
背景资料
The protein encoded by this gene is the founding member of the protein tyrosine phosphatase (PTP) family, which was isolated and identified based on its enzymatic activity and amino acid sequence. PTPs catalyze the hydrolysis of the phosphate monoesters specifically on tyrosine residues. Members of the PTP family share a highly conserved catalytic motif, which is essential for the catalytic activity. PTPs are known to be signaling molecules that regulate a variety of cellular processes including cell growth, differentiation, mitotic cycle, and oncogenic transformation. This PTP has been shown to act as a negative regulator of insulin signaling by dephosphorylating the phosphotryosine residues of insulin receptor kinase. This PTP was also reported to dephosphorylate epidermal growth factor receptor kinase, as well as JAK2 and TYK2 kinases, which implicated the role of this PTP in cell growth control, and cell response to interferon stimulation. Two transcript variants encoding different isoforms have been found for this gene. [provided by RefSeq, Jul 2013]

产品应用
| 应用 | 已检合格种属 | 预测种属 | 推荐稀释比例 |
|---|---|---|---|
| WB | Human | Mouse, Rat | 1:500-2000 |
| IHC-P | Human, Mouse, Rat | 1:200-500 | |
| IHC-F | Human, Mouse, Rat | 1:200-500 | |
| IF | Human, Mouse, Rat | 1:200-500 | |
| Flow-Cyt | Human, Mouse, Rat | 1:50-100 | |
| ICC/IF | Human, Mouse, Rat | 1:50-200 |
交叉反应
交叉反应: Human, Mouse, Rat
相关产品
暂无相关产品
靶标
基因名
PTPN1
蛋白名
Tyrosine-protein phosphatase non-receptor type 1
亚基
Interacts with EPHA3 (phosphorylated); dephosphorylates EPHA3 and may regulate its trafficking and function.
亚细胞定位
Endoplasmic reticulum membrane; Peripheral membrane protein; Cytoplasmic side. Note=Interacts with EPHA3 at the cell membrane.
组织特异性
Most abundant in testis. Also found in kidney, spleen, muscle, liver, heart and brain.
翻译后修饰
Ser-50 is the major site of phosphorylation as compared to Ser-242 and Ser-243. Activated by phosphorylation at Ser-50.
S-nitrosylation of Cys-215 inactivates the enzyme activity.
Sulfhydration at Cys-215 following endoplasmic reticulum stress inactivates the enzyme activity, promoting EIF2AK3/PERK activity.
S-nitrosylation of Cys-215 inactivates the enzyme activity.
Sulfhydration at Cys-215 following endoplasmic reticulum stress inactivates the enzyme activity, promoting EIF2AK3/PERK activity.
功能
Tyrosine-protein phosphatase which acts as a regulator of endoplasmic reticulum unfolded protein response. Mediates dephosphorylation of EIF2AK3/PERK; inactivating the protein kinase activity of EIF2AK3/PERK. May play an important role in CKII- and p60c-src-induced signal transduction cascades. May regulate the EFNA5-EPHA3 signaling pathway which modulates cell reorganization and cell-cell repulsion
标记抗体
暂无标记数据
同靶标产品
暂无同靶标产品
相关文献
提示: 发表研究结果有使用 bsm-60700R 时请让我们知道,以便我们可以引用参考文章。作为回馈,资料提供者将获得我们送上的小礼品。
暂无相关文献
常见问题
暂无常见问题